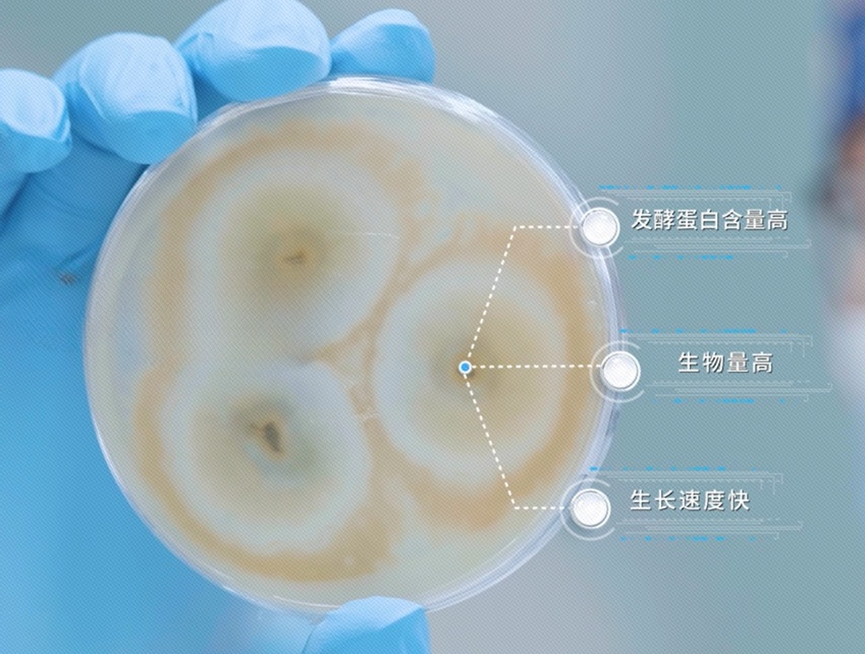
菌株筛选

2024年12月20日,中国菌丝蛋白创新企业蘑米生物宣布,其新一代自研菌株生产的菌丝蛋白产品已获得美国gras市场准入,成为中国首家取得该认证的菌丝蛋白企业。
什么是菌丝蛋白呢?菌丝蛋白又称菌肉,不同于植物肉、细胞培养肉,菌丝蛋白“向微生物要蛋白”,通过对真菌进行活化培养、液体发酵,以及过滤、热处理等系列工艺,获得最终的菌肉原料。
在海外,菌丝蛋白已有近四十年的安全食用历史、在全球近二十个国家和地区获批上市。但相比于国外的成熟应用,国内相关领域还处于探索阶段。而蘑米生物菌丝蛋白取得美国gras认证,率先打通了国内微生物蛋白产品的出海路径,填补了国内企业在该领域的空白。
目前,蘑米生物已构建起菌株发现、菌株筛选、发酵生产、食品开发的全产业链,菌种资源库保藏约30万株菌株,建立了完善的菌种资源储备,同时建有规模化的真菌发酵中试工厂、后处理设施,并与印尼、马来西亚、芬兰等国家的客户达成了1000吨/年的拟采购协议。国内多家知名食品全产业链企业,也与蘑米生物就菌肉原料共同开发、样品测试等开展合作。
通过本文,您可了解到关于菌丝蛋白现状、趋势、优势、应用以及蘑米生物方面的更多信息。
目录
一、什么是菌丝蛋白?
二、蘑米生物菌丝蛋白优势
三、蘑米菌丝蛋白应用方向
四、蘑米生物是谁?
五、核心团队
六、全产业链技术平台
七、企业荣誉
八、联系蘑米生物
九、参考来源
一、什么是菌丝蛋白?
(一)定义和发展

图片来源:mushroomrevival
以大众熟悉的真菌生物——蘑菇举例,平时消费者食用的,通常是可食用真菌的“枝干”——子实体;而菌丝蛋白,则是由真菌的“根部”——菌丝体,加工得到的。
菌丝体是真菌的营养器官,类似植物的根部,由无数条分支菌丝构成。20世纪60年代,英国研究人员发现菌丝中蕴含丰富的蛋白质,由此开启了对菌丝蛋白的探索和利用。
通过菌种筛选、改造,研究人员培育出适合的菌株。菌株在发酵罐中进行培育,使菌丝体快速生长,随后经过一系列过滤、热处理等工艺,就得到了可食用、与肉类相似的“菌肉”(菌丝蛋白)。
菌丝蛋白的蛋白质含量可达50%以上,膳食纤维含量可达35%以上,无豆腥或动物腥味,并因其中的纤维结构,更具真实肉感。此外,菌丝蛋白生产效率很高,相较传统畜牧业可提升数十至数百倍,在规模化生产过程可节省90%以上的土地、水资源,并减少94%的温室气体排放,具有可持续属性。
20世纪70年代中期,经过研究测试,菌丝蛋白被确认适合人类消费,并可以进行大规模生产及销售。1985年,英国批准菌丝蛋白用于食品;同年1月,英国开始销售菌丝蛋白食品。迄今为止,菌丝蛋白已有近40年的食用历史,并在近20个国家销售。
(二)全球市场趋势
随着人们的认知不断深入,传统蛋白质的供应困境和新的健康追求,越发成为国际共同关注的问题:
- 需求增长:联合国粮农组织相关负责人提出,“到2050年,世界人口预计将达到近100亿人,届时全球对肉类、蛋类和乳制品等动物源性食物的需求将增长20%”;[1]
- 资源消耗:根据粮农组织的分析,畜牧业及上游的饲料生产环节已占用了大量水、土地资源,而过度放牧还会导致自然资源的退化;[2]
- 温室效应:根据国际咨询公司deloitte的分析,全球畜牧业每年产生二氧化碳超80亿吨,产生的温室气体占全球排放量的16.5%;[3]
- 健康追求:后疫情时代下,消费者的健康消费理念及生活方式发生转变。根据贝恩全球消费者实验室最新发布的报告显示,在全球范围内,76%的消费者认为可持续的生活方式很重要;[4]
在全球人口增长、资源短缺、环境危机,以及消费者对膳食健康越发关注的背景下,替代蛋白越来越成为解决问题的重要方案。波士顿咨询公司(bcg)的研究报告显示,2035年替代蛋白市场规模将有望达到2900亿美元,其中微生物发酵蛋白占有约1/5的市场规模。[5] 根据罗兰贝格的调研,截至2020年12月,发酵蛋白领域已披露的融资交易超过了110轮。[6]
中国作为世界上最大的食品进口国,肉类及其制品是最大的进口食品项目,[7] 确保肉类资源的稳定和安全供给至关重要。2022年3月,《加快建设农业强国 推进农业农村现代化》提出,“要发展生物科技、生物产业,向植物动物微生物要热量、要蛋白”。[8] 2024年8月,国家标准化管理委员会、国家市场监督管理总局发布《素肉制品术语与分类(gb/t 44336-2024)》,明确了“微生物基素肉制品”的产品分类,为我国菌丝蛋白行业提供了指引。[9]
二、蘑米生物菌丝蛋白优势

图片来源:神农架国家公园
我国的真菌种类繁多,生物多样性极为丰富,但菌丝蛋白开发利用仍处于基础阶段。蘑米生物从近30万的菌种资源库中,筛选出来源于北纬31度神农架的菌丝蛋白菌株进行培育,填补了国内相关领域的空白,并打造出具有优势的菌肉原料产品。
(一)味道和质地

(二)营养丰富
|
蛋白质来源 |
pdcaas评分 |
|
牛肉 |
0.92 |
|
鸡肉 |
0.95 |
|
蘑米菌肉 |
1.0 |
|
乳清蛋白 |
1.0 |
|
酪蛋白 |
1.0 |
蛋白质来源pdcaas评分
同时,菌丝蛋白相较传统畜牧业无抗生素风险,和植物蛋白生产过程相比无农药残留风险,产品清洁无污染,生产过程可追溯,是理想的蛋白原料。
(三)生产效率

(四)环境效益

三、蘑米菌丝蛋白应用方向
|
对应人群 |
产品价值 |
|
营养补充人群 |
高蛋白含量、高纤维含量,含磷、钾、钙、铁等微量元素,以及各类人体必需氨基酸 |
|
素食主义者 |
优良的非动物来源蛋白,兼顾素食需要和口味追求 |
|
体重管理人群 |
高膳食纤维,饱腹感强,低脂低卡,助力体重管理 |
|
健身人群 |
高蛋白含量,助力有效增肌 |
|
银发人群 |
高蛋白质含量,0胆固醇,对维持肌肉水平、维护心血管健康有积极影响 |
(一)主食类

(二)肉食类

(三)零食类

图片来源:freepik
蘑米菌肉也可应用到和休闲食品品牌合作开发的营养丰富的素食零食产品中,如手撕菌肉、菌肉干、菌肉脯、菌肉辣条等。
(四)代餐类

图片来源:freepik
在代餐产品领域,蘑米菌肉也可用于即食鸡胸肉产品中,打造相较于传统产品热量更低(仅为鸡胸肉的一半)、膳食纤维含量更高的代餐产品。蘑米菌丝蛋白也可用于蛋白棒产品的生产,通过混合动物、植物、微生物蛋白,打造低脂低卡、高膳纤、高饱腹、多重营养的蛋白棒。
(五)蛋白饮料

- 不腥膻:无传统奶制品可能存在的膻味或豆制品的腥味
- 味道:真菌发酵,保留轻微类似蘑菇的独特味道,添加适量甜味剂后相对温和自然
- 口感:具有一定的浓稠度,带来较为浓厚的口感
- 营养:兼具牛奶与植物奶优势,既含有蛋白又含膳食纤维,不含乳糖和碳水,热量低
| 项目 | 菌乳 | 牛奶 | 植物奶 |
|
蛋白质 (g/100ml) |
2.5 | 3.0 | 2.5 |
|
脂肪 (g/100ml) |
0 | 4.0 | 1.7 |
|
膳食纤维 (g/100ml) |
1.3 | 0 | 0.6 |
|
钠 (mg/100ml) |
0 | 45 | 0 |
|
碳水 (g/100ml) |
0 | 4.5 | 7.2 |
|
能量 (kj) |
43 | 278 | 228 |
菌乳&牛奶&植物奶营养成分对比
四、蘑米生物是谁?
(一)九游会的简介

(二)发展历程
2017年,慕恩(广州)生物科技有限公司(广州总部)正式启用,生产中试基地建成;
2019年,蝉联“中国最具投资价值企业50强”,“粤港澳大湾区生物科技创新企业50强”;
2022年,蘑米生物(moremeat)注册成立;
2023年,蘑米生物建立了工业发酵组学分析技术平台和基于代谢网络精准指导发酵工艺设计和优化的技术平台,建设完成真菌蛋白吨级中试发酵车间。
2024年,蘑米生物完成fssc22000安全生产体系搭建和认证,同年12月取得美国gras认证,获准进入美国市场。
五、核心团队
- 刘杏忠 教授 联合创始人、首席科学家
国家杰出青年科学基金获得者(国家杰青)、南开大学教授、中国科学院微生物研究所研究员、中科院百人计划入选者,享受国务院政府特殊津贴。刘杏忠教授曾任真菌学国家重点实验室主任、中国菌物学会理事长、亚洲菌物学会主席、《mycology》主编,长期从事真菌进化生物学及应用研究。
- 蒋先芝 博士 联合创始人、董事长
中科院微生物研究所博士、慕恩生物创始人,长期从事微生物组资源的发掘、筛选和应用开发。2010年,蒋先芝博士加入丹麦诺维信公司,担任高级科学家;2015年创立慕恩生物。蒋先芝博士是广州开发区创业领军人才、教育部“科技进步一等奖”获得者、国家十四五重点专项主持人,获国际、国内发明专利数十项。
- 田灵芝 博士 首席运营官
江南大学发酵工程专业博士,长期从事合成生物学及发酵工程等相关研究,擅长工业微生物底盘细胞构建、系统代谢调控、发酵工艺优化及工业化放大。田灵芝博士在国际知名学术期刊发表研究论文十余篇,申请或授权的国际、国内发明专利数十项。从0到1主导多项基于微生物制剂的lbps和微生物蛋白新原料的国内外注册申报。
六、全产业链技术平台
蘑米生物目前已建立起从菌株发现、菌株筛选、发酵生产到配方开发的完整技术平台,具备独立完成真菌蛋白产品研发及制作的能力,是国内新蛋白领域菌丝蛋白行业的先行者。
(一)菌株发现

蘑米生物拥有全球最大的菌种资源库之一,保藏约30万株菌株;生物多样性高,菌种来自于自然环境,包括极端环境、动植物体内等。其中,重要真菌fusarium相关菌株分离保存超过7000株、200种。
(二)菌株筛选
(三)发酵生产

(四)食品开发

七、企业荣誉
- 国家高新技术企业
- 教育部科技进步一等奖
- 广东省微生物育种与创新应用(慕恩)工程技术研究中心
- 国家菌种资源库(华南生物技术中心)
- 广东省知识产权示范企业
- 红杉中国智能医疗基因组学孵化器(因美纳技术驱动)第二期九强企业
- ifa2023未来农业食品百强
- ipia创新蛋白挑战赛潜力奖
- 2024全国颠覆性技术创新大赛优胜奖
八、联系蘑米生物


(添加请备注姓名 公司 职位)
九、参考来源
文中菌丝蛋白的蛋白含量和膳食纤维数据均为干基状态结果
本文作者:isaac,foodtalks
foodtalks什么是系列公司内容策划帮助食品企业更清晰、更完整、更通俗易懂、更有趣地呈现企业信息。
什么是系列公司内容策划帮助企业打造线上的企业名片,让用户通过一篇文章了解企业的全部!(详细请参考:合作方案 & 合作案例)

相关合作:
|
项目 |
介绍 |
合作方案 |
|
foodtalks 什么是系列公司策划 |
什么是系列,打造线上的企业名片 |
|
|
fbif & foodtalks 视频策划 |
视频策划,打造企业视频名片 |
|
|
foodtalks 食品雷达 |
已收录6000 家优质企业 |
|
|
更多合作,请点击: |
||
加入fbif植物肉群

(添加请备注:姓名 公司 职位)
关注foodtalks什么是系列公众号

![]()
点击获取更多九游会

 foodtalks
foodtalks
 2,303
2,303

 2
2






